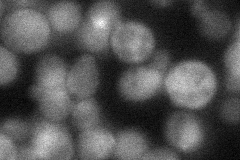
YDR309C
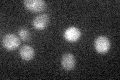
YDR309C

View description
Redundant rho-like GTPase Cdc42p effector; homolog of Gic1p; involved in initiation of budding and cellular polarization; interacts with Cdc42p via the Cdc42/Rac-interactive binding (CRIB) domain and with PI(4,5)P2 via a polybasic region
Localization:
Intensity:
Fold change:
Significance:
-
C’ GFP library in SD

cytosol19.04 -
N' NOP1pr-GFP in SD

cytosol44.1291 -
N' TEF2pr-mCherry in SD

cytosol17.1245 -
N' NATIVEpr-GFP in SD
cytosol36.4182 -
N' TEF2pr-VC and Cyto-VN in SD

below threshold23.2564 -
C’ GFP library in SD+DTT

cytosol17.90.94No -
C’ GFP library in SD+H2O2

cytosol21.21.11No -
C’ GFP library in Starvation Media
cytosol25.531.34No -
C’ GFP library on the background of Pup2-DaMP

cytosol -
C’ GFP library on the background of CCT mutant

cytosol17.87240.938489No
